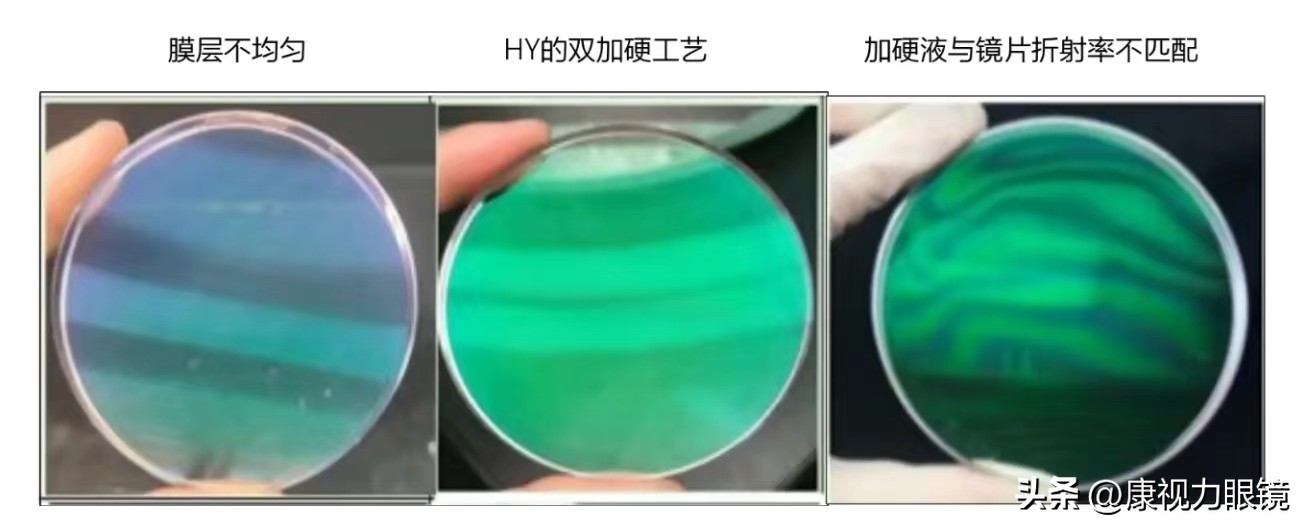

便宜镜片跟贵镜片的区别是什么?
贵的镜片比如蔡司,尼康,罗敦司得。这些品牌的功能型镜片动辄几万甚至十来万。
便宜的比如某夕夕一整副眼镜买下来甚至能给你9.9包邮。
贵的镜片是智商税吗?
答案
自然不是。刨除验配技术,服务价格,单纯只看镜片。贵的镜片好在以下几点。

①准确的度数
度数的准确性直接影响顾客佩戴的清晰度,甚至舒适度。差的镜片,度数偏差可能会比较大。比如有的时候,我们发现顾客的眼镜是同等的度数,但是配出来,就是新的眼镜这个清晰度还差一点,那有没有可能,是这副新的眼镜,度数偏差比较大呢,而这位客户眼睛是比较敏感的,差个十几度是能感知到的。

边缘视野变形更小
②优异的材料
目前市面上的镜片大部分都是树脂材质。在镜片的外形上似乎很难看出差异,可通过折射率、光学性能、抗冲击性、易加工性、耐候性、耐久性来查验评估的。我们消费者最直观的看折射率,折射率影响阿贝数,阿贝数可以简单的理解约等于清晰度,1.50的镜片接近于裸眼看的效果。好的镜片韧性,抗冲击、耐压性更强

边缘视野更宽广
③好的膜层(防静电,防油污,防紫外线)
镜片膜层是覆盖在镜片基材上的一层很薄氧化混合物。膜层直接影响镜片的硬度,吸灰能力,防油污能力,防紫外线能力等。当然还有很重要的透光率!
试想一下,膜层差的镜片。透光率低,必然清晰度下降。防静电能力差,一直吸灰,镜片总是灰蒙蒙的。硬度不够,没几个月遍布划痕。

④镜片的功能、舒适的设计
青少年的防控镜片。解决小孩子度数增长过快
老年人渐进镜片。解决老年人既有近视又得老花,两副眼镜轮换戴的麻烦
驾驶镜片。解决开车大灯眩光的烦恼
这类功能型的镜片,价格就远远高于普通单光。
功能越多,价格越贵。贵在不单单只是解决屈光不正的问题(屈光不正简单理解:近视,散光,远视

总结:不同价位镜片区别主要在品牌,品控,材质,镀膜,功能等因素。好的镜片往往价格不便宜。
当然,镜片也不是越贵越好,适合自己就行。希望大家都能选到合适的镜片。
标签:
119
“你咋不上天呢”是什么梗?你咋不上天呢来源出处在哪里? 最近常常在网络上见到的那句话“你咋不上天呐”是个什么梗?你咋不上天呢来源出处在哪里? 东北的娃儿可以去操场玩...
184
天才儿童的定义:天才儿童是什么? 古今中外有许多表现非凡的儿童存在,人们对他们的认识由于时代局限、国界和文化的差异称呼而不同。如在俄罗斯教育学的词汇中“天才”是不受...
142
老子诠真65:圣人即将出世?你知道什么样的人才算是圣人吗? 有预言说圣人在2022年出世,所以很多人在议论这个话题。可是,如果连什么样的人才算是圣人都不知道,那是瞎议论。《...
165
看到女博主说炒股失败,有可能会跳河跳楼!我们应吸取什么教训? 今天看到一个叫什么猫猫的女博主。她说一月份亏了五万块钱。今年最后一交易日,她还亏了一万多。她说撸了很多...
75
什么是整身如球?如何练就“千斤坠” 所谓“千斤坠”就是将一身之重量,加往下的速度,形成最大冲击力。在使用时,需要将纵方向的劲力通过转化,变化前后的劲力发放。因其使用...
67
“籍贯”是什么,何为籍,何为贯?为什么要填籍贯 在记忆中,自从上学读书以后,就填过无数的表格,比如学籍卡、求职表等等,凡是需要填写个人资料的表格,几乎都要求你填写一...
137
还有什么不敢卖?叙利亚黑市年轻女子被明码标价,最低只要67元 战争对于很多人来说可能都是比较遥远的一件事情,但在中东地区,它却每天都在发生。尤其是深受战乱影响的叙利亚...
98
读书的意义是什么? 当你开心的时候, 你可以说春风得意马蹄疾,一日看尽长安花, 而不是一句‘真开心’; 当你看到美女时, 你可以说‘北方有佳人,绝世而独立’而不是一句‘美...
186
“衣中茅台”比音勒芬,四千元一件的POLO衫,究竟有什么魔力? 尊敬的读者,感谢您在百忙之中能够阅读我的文章,这是对我努力的肯定,也是我持续创作的动力,向您致以我最诚挚的...
156
什么是土猪 什么是土猪?那正宗的土猪是如何养成的呢? 什么是土猪?一说起土猪,大家是不是就想起了农村家养的猪呢?家养的猪和正宗的土猪是一回事儿吗?正宗的土猪又是如何...
112
农村房顶装的光伏发电有没有辐射?是骗局吗?究竟会造成什么危害 随着可再生能源的普及,越来越多的农村家庭开始在自家房顶安装光伏发电系统。然而,关于光伏发电是否存在辐射...
147
酸枝木是什么树? 根据有关文献记载,“酸枝木”这个名称是我国明代和清代出现的,在明清时期的高级家具所用木材主要以紫檀和黄花梨为主,尽管酸枝木在明代家具中已经有应用,...
71
女生说你烦是什么意思,推荐十个高情商回复! 导语: 在日常生活中,女生对男生的评价有时会让人摸不着头脑。特别是当她们说“你真烦”时,很多男生都会感到困惑和不安。 今天...
178
路透社:什么是 DeepSeek 以及它为什么会颠覆 AI 领域? (路透社)——中国初创公司 DeepSeek 推出了最新的人工智能模型,据称这些模型与美国行业领先的模型相当甚至更好,而成本却只...
159
「足部疼痛地图」足底不同部位的疼痛,分别预示着什么问题? 脚是人的基础,足部出现疼痛,必然会给我们的生活带来影响。 而不同部位的疼痛,通常预示着不同的疾病。 我们可以...
78
吴王孙坚是怎么死的?他的死和袁术有什么关系? 吴王孙坚((155年—191年),字文台。东汉末年的将领、军阀,孙吴政权的奠基者之一。据传为春秋时期军事家孙武的后裔。) 孙家...
52
你知道什么是大三元镜头,什么是小三元镜头吗 你是不是经常听到或者看到人家聊摄影时,时不时出现大三元、小三元这些摄影“黑话”,是不是有点摸不着头脑,虽然知道人家说的是...
188
基辅是乌克兰的首都,但在俄罗斯人眼里,有着什么特殊的意义? 基辅市是乌克兰的首都,也是乌克兰的直辖市,以及基辅州的首府。这座城市的人口约为296万人,面积约为839平方公里...
185
英国脱欧是什么操作,英国为何要退出欧盟 戳右边点关注,茶余饭后,带您足不出户观世界! 前段时间,英国脱欧成功,成为历史上第一个脱离欧盟的国家。英国脱欧的行为,让很多...
175
来新疆摘棉花是种什么样的体验?孙芳红这样说! 每年棉花采摘季,除了 机械化采收 ,也有少量棉田需要 人工采摘 ,作为机械化采收的有效补充。采棉工或自发、或由劳务经纪人组...